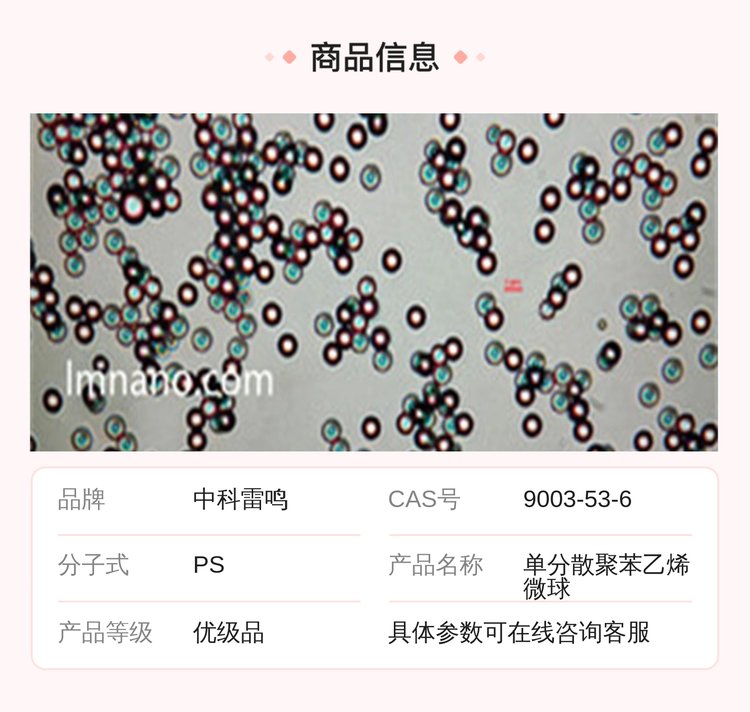

商品详情
| 产品参数 | |||
|---|---|---|---|
| 供应 单分散聚苯乙烯微球 多种规格尺寸 100nm 50mg/ml 品牌 | 中科雷鸣 | ||
| CAS号 | 9003-53-6 | ||
| 分子式 | PS | ||
| 产品名称 | 单分散聚苯乙烯微球 | ||
| 产品规格 | 100nm 50mg/ml 10g | ||
| 产品类型 | 抗体 | ||
| 储存条件 | 常温常湿 | ||
| 有效成分含量 | 99 | ||
| 保质期 | 三年 | ||
| 用途范围 | 用于标准计量、医学免疫、生物工程、分析化学、化学工业及微电子等 | ||
| 是否进口 | 否 | ||
| 含量 | 50mg/ml | ||
| 自重 | 10g | ||
| 颜色 | 白色 | ||
| 粒径 | 100nm | ||
| 体积 | 10ml | ||
| 包装 | 1瓶 | ||
| 包装规格 | 1瓶/盒 | ||
| 可售卖地 | 全国 | ||
| 等级 | 优级品 | ||

.jpg)
.jpg)

.jpg)